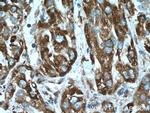
CYB5R3 Antibody in Immunohistochemistry (Paraffin) (IHC (P))
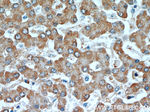
CYB5R3 Antibody in Immunohistochemistry (Paraffin) (IHC (P))

Search
Proteintech
CYB5R3 Monoclonal Antibody (9C4D10)
{{$productOrderCtrl.translations['antibody.pdp.commerceCard.promotion.promotions']}}
{{$productOrderCtrl.translations['antibody.pdp.commerceCard.promotion.viewpromo']}}
{{$productOrderCtrl.translations['antibody.pdp.commerceCard.promotion.promocode']}}: {{promo.promoCode}} {{promo.promoTitle}} {{promo.promoDescription}}. {{$productOrderCtrl.translations['antibody.pdp.commerceCard.promotion.learnmore']}}
产品信息
66022-1-IG
种属反应
宿主/亚型
分类
类型
克隆号
抗原
偶联物
形式
浓度
规格
纯化类型
保存液
内含物
保存条件
运输条件
产品详细信息
Immunogen sequence: MGAQLSTLG HMVLFPVWFL YSLLMKLFQR STPAITLESP DIKYPLRLID REIISHDTRR FRFALPSPQH ILGLPVGQHI YLSARIDGNL VVRPYTPISS DDDKGFVDLV IKVYFKDTHP KFPAGGKMSQ YLESMQIGDT IEFRGPSGLL VYQGKGKFAI RPDKKSNPII RTVKSVGMIA GGTGITPMLQ VIRAIMKDPD DHTVCHLLFA NQTEKDILLR PELEELRNKH SARFKLWYTL DRAPEAWDYG QGFVNEEMIR DHLPPPEEEP LVLMCGPPPM IQYACLPNLD HVGHPTERCF VF (1-301 aa encoded by BC004821)
靶标信息
CYB5R3 (NADH-cytochrome b5, reductase 3, diaphorase 1) is a 301 amino acid protein encoded by the human gene CYB5R3. CYB5R3 belongs to the flavoprotein pyridine nucleotide cytochrome reductase family and has two naturally occuring isoforms. Isoform 1 is anchored to the cytoplasmic side of the endoplasmic reticulum membrane and mitochondrion outer membrane, while isoform 2 is the soluble form found in erythrocytes. CYB5R3 is involved in the desaturation and elongation of fatty acids, cholesterol biosynthesis,drug metabolism and, in erythrocytes, methemoglobin reduction.
仅用于科研。不用于诊断过程。未经明确授权不得转售。
篇参考文献 (0)
生物信息学
蛋白别名: B5R; DIA1; Diaphorase-1; Diaphorase1; mutant NADH-cytochrome b5 reductase; NADH cytochrome b5 reductase (EC 1.6.2.2); NADH-cytochrome b5 reductase 3; NADH-cytochrome b5 reductase 3 membrane-bound form; NADH-cytochrome b5 reductase 3 soluble form; unnamed protein product
基因别名: B5R; CYB5R3; DIA1
UniProt ID: (Human) P00387
Entrez Gene ID: (Human) 1727